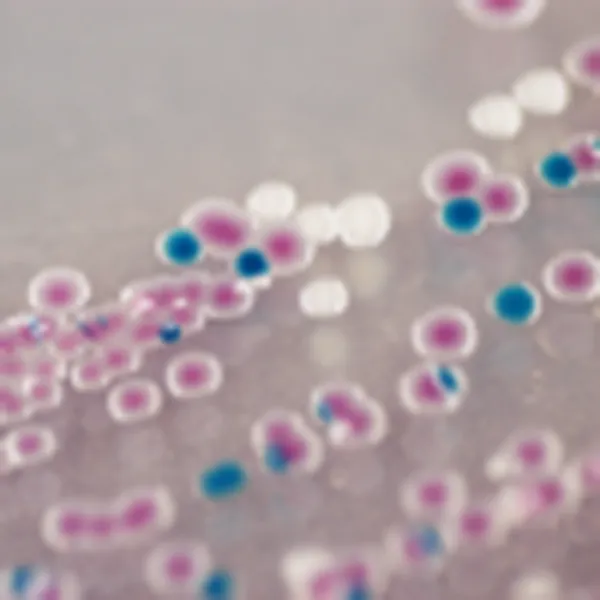
CHROMagar™ Vibrio

Hình thái khuẩn lạc

Clostridium perfringens
màu cam

C. difficile
màu xanh dương-xanh lá cây đến xanh lá cây
Hiệu năng
Hiệu năng
Clostridium perfringens có liên quan đến ngộ độc thực phẩm và nhiễm trùng trên động vật. Thịt bò, gia cầm, nước sốt và thức ăn khô hoặc tiền chế biến là những nguồn phổ biến gây nhiễm C. perfringens. Nhiễm C. perfringens thường xảy ra khi thực phẩm được chuẩn bị với số lượng lớn và giữ ấm trong thời gian dài trước khi phục vụ.
Mặc dù C. perfringens có thể tồn tại bình thường trong ruột người, bệnh xảy ra khi ăn thực phẩm nhiễm vi khuẩn C. perfringens với số lượng lớn đến mức sản sinh đủ độc tố trong ruột để gây bệnh.
Mọi người đều có nguy cơ ngộ độc thực phẩm từ C. perfringens. Người rất trẻ và người cao tuổi có nguy cơ cao nhất bị nhiễm C. perfringens và có thể trải qua các triệu chứng nghiêm trọng hơn, có thể kéo dài từ 1 đến 2 tuần. Các biến chứng, bao gồm mất nước, có thể xảy ra trong các trường hợp nghiêm trọng.
CDC - Trung tâm Kiểm soát và Phòng ngừa Dịch bệnh
1. Được sử dụng với phương pháp đổ hoặc phương pháp bề mặt bằng cách streak trực tiếp, trải hoặc kỹ thuật lọc) trong khi với môi trường TSC, vi khuẩn cần được đặt giữa hai lớp thạch để mọc thành khuẩn lạc màu đen.
2. Môi trường đặc hiệu cho Clostridium perfringens trong khi môi trường TSC phát hiện vi khuẩn khử sulfate, bao gồm cả vi khuẩn không gây bệnh.
3. Màu cam giúp dễ dàng quan sát mặt khác, việc khuếch tán màu đen của khuẩn lạc và thực tế là chúng mờ dần theo thời gian trong môi trường TSC (như đã mô tả trong ISO 14189) khiến việc đếm khuẩn lạc trở nên khó khăn.
Thành phần

Tài liệu kỹ thuật
Công bố khoa học
2020
A comparative study on the use of selective media for the enumeration of Clostridium perfringens in poultry faeces
? Publication2020
Study of an acid phosphatase test for the confirmation of Clostridium perfringens directly from CHROMagar C.Perfringens agar medium
? Publication

Xem thêm